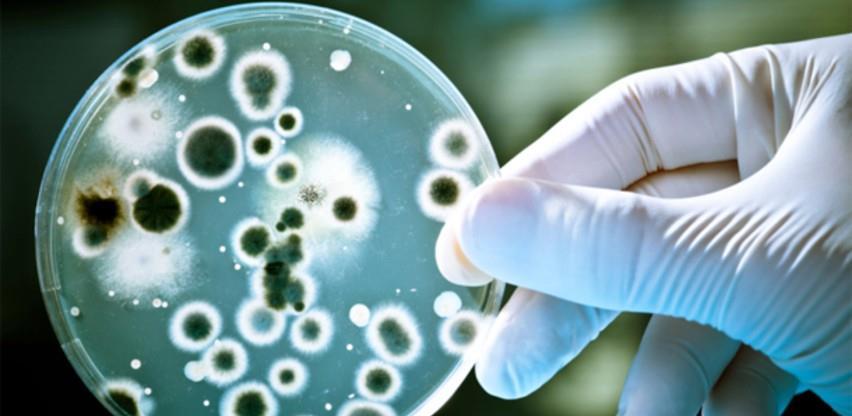

16.08.2021 |
Vijesti / BOSNA I HERCEGOVINA
Izvor: Akta.ba
Firma Grizelj je izabrana za dobitnika prestižne poslovne nagrade za izvrsnost "THE BIZZ".
*Pri preuzimanju teksta s portala Akta.ba potrebno je navesti izvor i linkovati tekst.
Dojavi vijest na viber +387 60 331 55 03 ili na mail urednik@akta.ba.